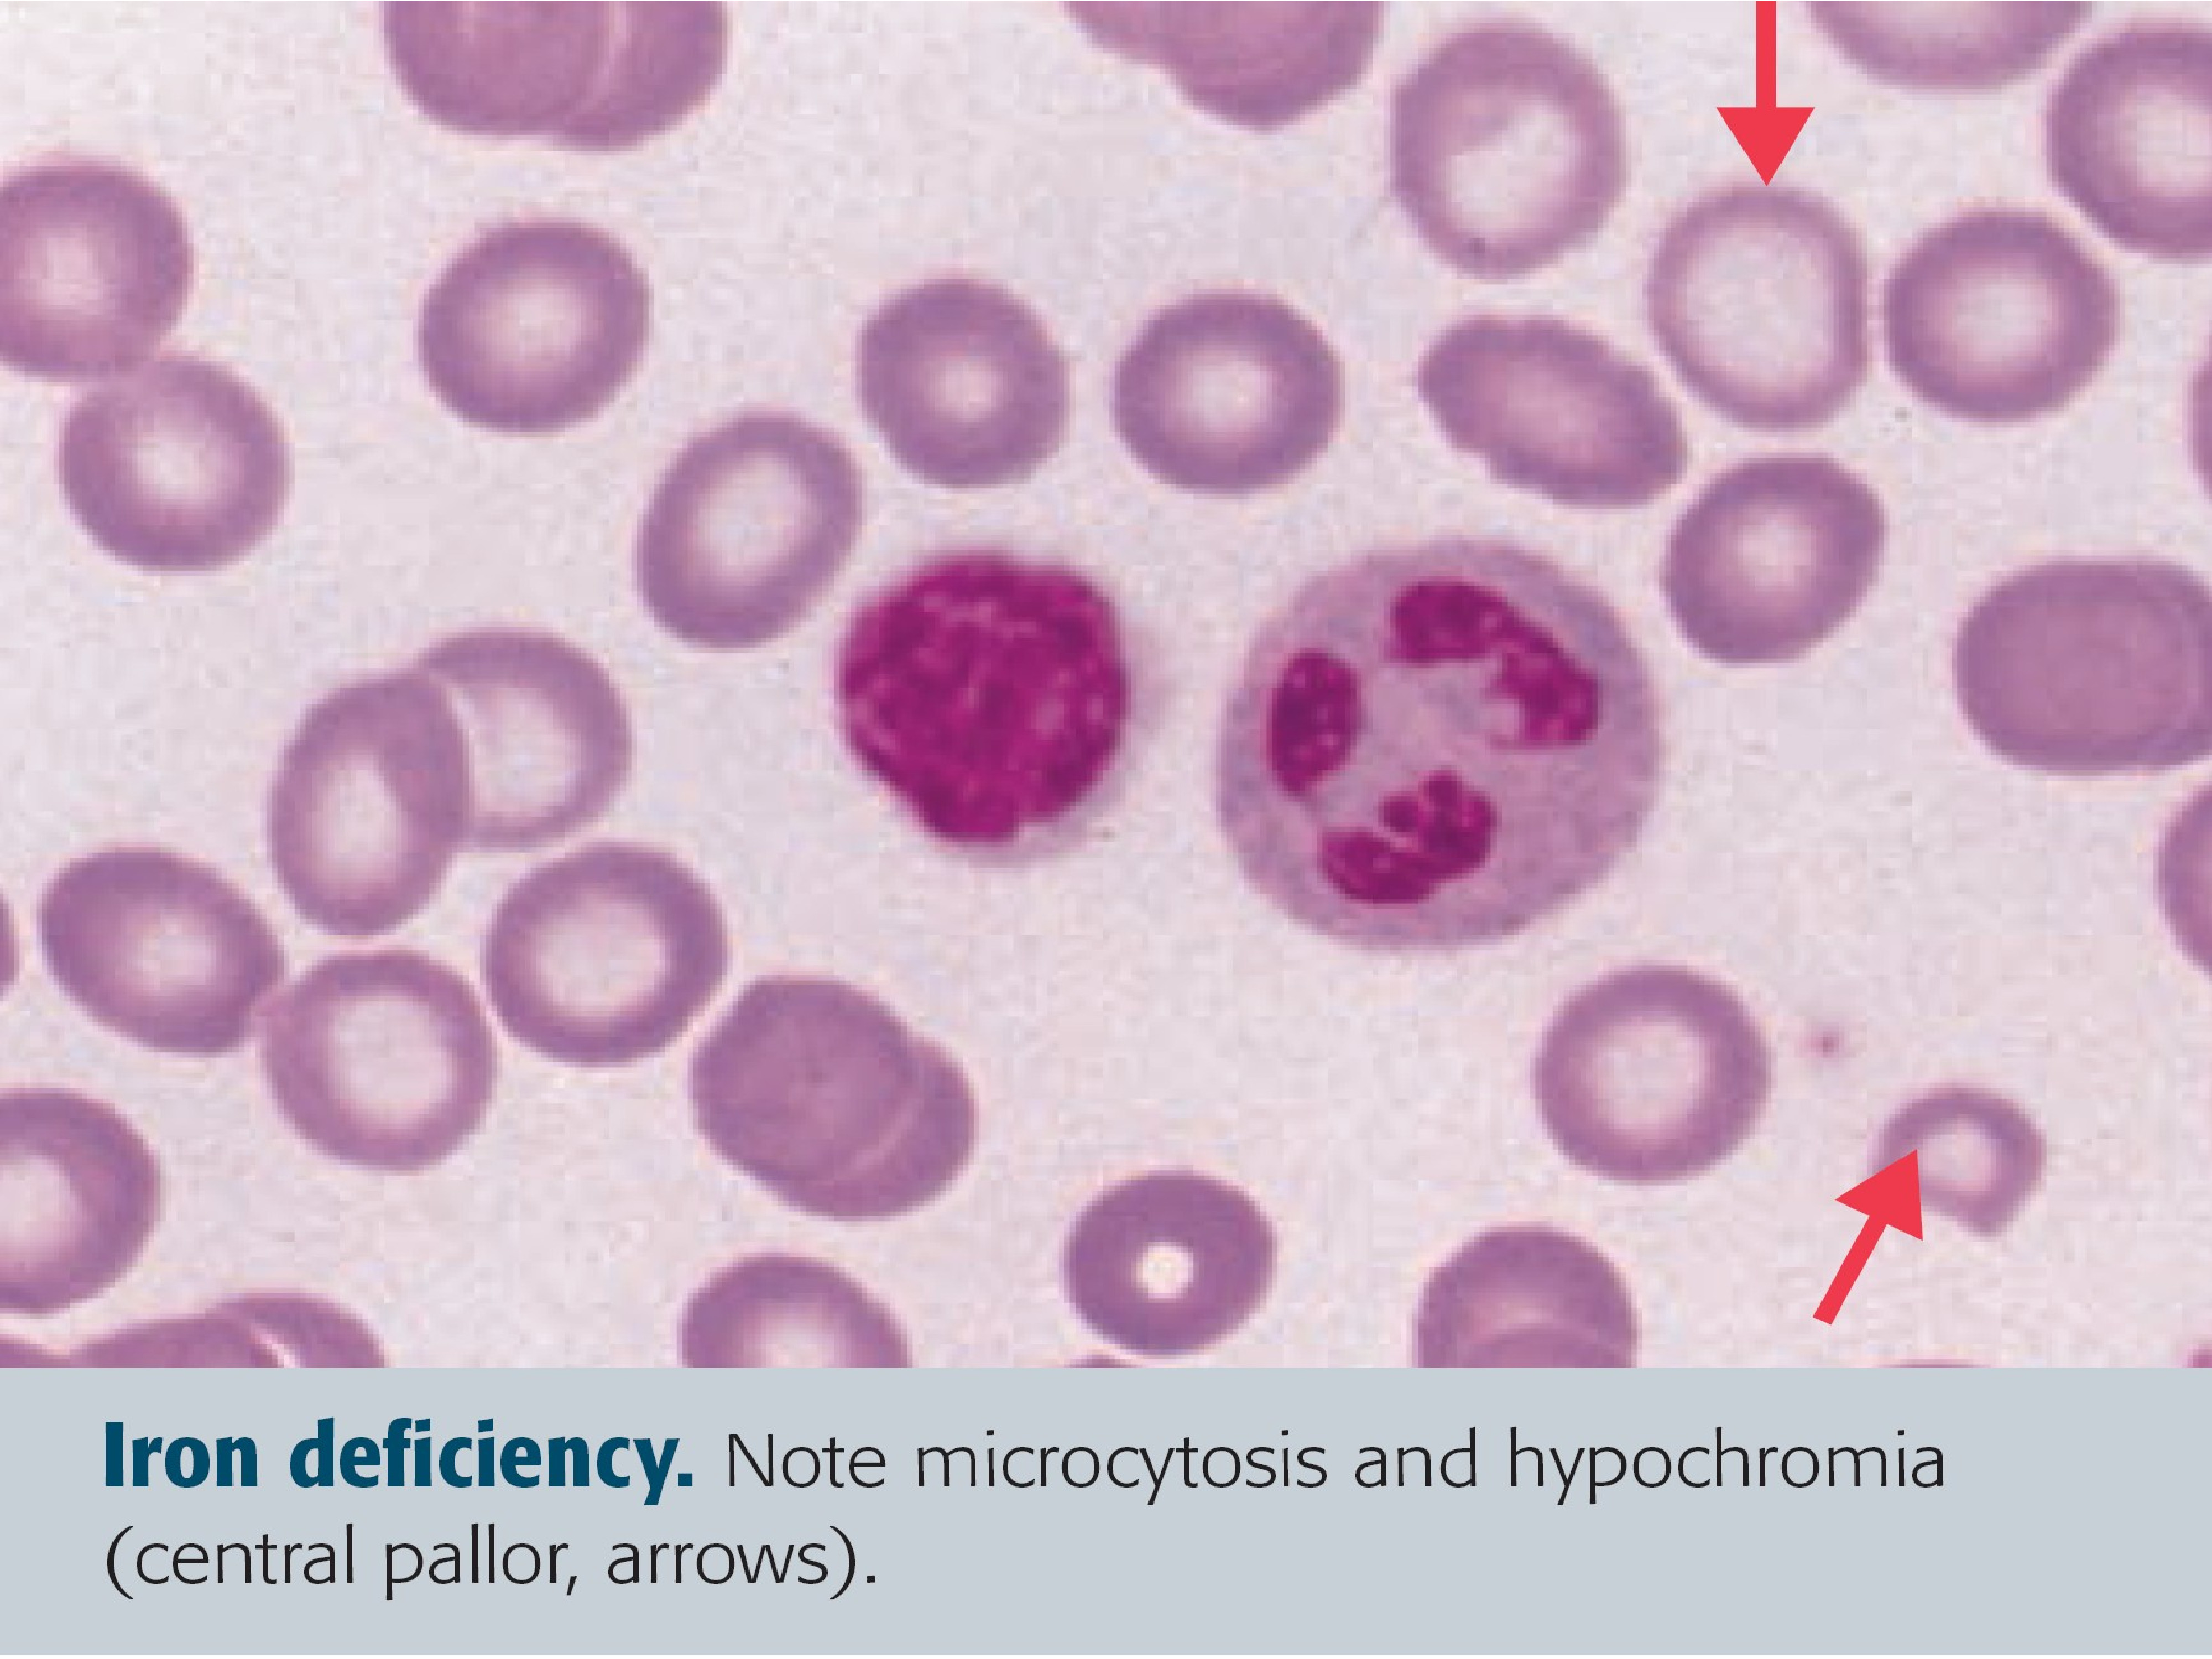

Гемоглобин микроцитоз
Друг денег дороже смысл пословицы
Шары с доставкой воронеж
Какие растения приспосабливаются к среде обитания
Systems analysis and control
Гомеопатия фото
Для тех людей которые желают
Eotech 552
Танец мальчики и девочки детский
Розетка pce schuko
Сделать прививку от гриппа ярославль
Авто в кредит в новороссийске
Честер барнаул
Аккорды песни очарована
Гемоглобин микроцитоз 113 фото